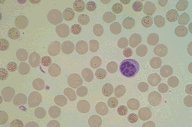

Description
Hereditary spherocytosis: A normal lymphocyte and many
spherocytic red cells are seen in this high dry
magnification view of the Wright's stained peripheral blood.
|
|
Click on this image
to enlarge it, then
on Back buttom
in the Netscape Menu
to shrink it back down



|